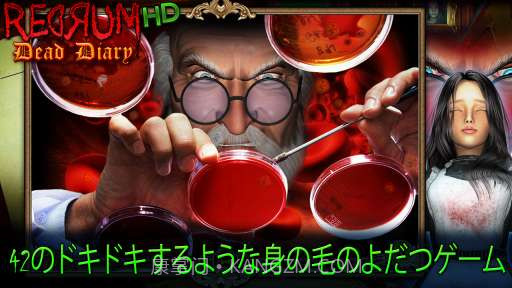
死亡日记 Redrum Dead Diary截图1

应用介绍
软件介绍
死亡日记这款游戏让我深陷其中,绝对是个不错的解谜佳作。每个案件都有独特的线索,玩起来像是在跟着小玫一起推理,既刺激又有趣!恐怖元素适度,不会让你太害怕,但又能保持悬疑感,非常适合喜欢思考的人。在上班路上玩几局,轻松解压,还能跟朋友聊剧情,让人倍感愉悦,真的是休闲时光的不二之选。
使用场景
非常好融入日常,无论上下班还是睡前,都能来几局放松一下。偶尔替代手机刷短视频,也挺不错。
在休闲活动中,非常适合放松心情
睡前放松脑筋,别让鬼魂缠着你
技术特点
画面风格很有氛围,但细节有点不足
优化不是特别完美,有时候加载慢
操作手感算是流畅,不过偶尔卡顿
常见问题
如何快速上手死亡日记?
新手上手不难,大概玩几局就能熟悉了,可以先了解一下案件类型和逻辑线索。
每个案件有多少时间限制吗?
游戏并没有严格时间限制,但建议尽量在不受干扰的环境下认真思考,以便更好地推理和解决案件。
如果遇到卡顿现象该怎么办?
如果出现卡顿,可以尝试重启一下或者稍等片刻,有时候加载慢。不要着急,多试几遍就能解决!
用户评价
用户普遍反映死亡日记 Redrum Dead Diary使用体验良好,让你在繁忙生活中找到一丝乐趣获得好评。
相关推荐
软件截图
历史版本
v1.11
当前版本
16.4MB
2025-07-12